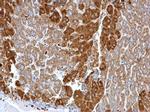
Glutamine Synthetase Antibody in Immunohistochemistry (Paraffin) (IHC (P))

Search
Invitrogen
Glutamine Synthetase Monoclonal Antibody (GT1055)
{{$productOrderCtrl.translations['antibody.pdp.commerceCard.promotion.promotions']}}
{{$productOrderCtrl.translations['antibody.pdp.commerceCard.promotion.viewpromo']}}
{{$productOrderCtrl.translations['antibody.pdp.commerceCard.promotion.promocode']}}: {{promo.promoCode}} {{promo.promoTitle}} {{promo.promoDescription}}. {{$productOrderCtrl.translations['antibody.pdp.commerceCard.promotion.learnmore']}}
图: 1 / 18
Glutamine Synthetase Antibody (MA5-27749) in ICC/IF

Please note: We are reviewing Western blot images included in the antibody testing data in our catalog, including those provided by third parties. Unless expressly labeled or annotated as “raw-unedited”, Western blot images included in the antibody testing data in our catalog may have been edited, optimized or otherwise adjusted for presentation.
产品信息
MA5-27749
种属反应
已发表种属
宿主/亚型
分类
类型
克隆号
抗原
偶联物
形式
浓度
规格
纯化类型
保存液
内含物
保存条件
运输条件
RRID
产品详细信息
Positive Control: 293T, HeLa, HepG2, U87-MG, SK-N-SH, IMR32, SK-N-AS, mouse brain, mouse eye, rat brain
Predicted Reactivity: Xenopus laevis (85%), Dog (97%), Pig (96%), Chicken (88%), Rhesus Monkey (100%), Chimpanzee (99%), Bovine (96%)
Store product as a concentrated solution. Centrifuge briefly prior to opening the vial.
靶标信息
Glutamine synthase is part of the glutamine synthetase family. Ammonia incorporation in animals occurs through the actions of glutamate dehydrogenase and glutamine synthase. Glutamate plays the central role in mammalian nitrogen flow, serving as both a nitrogen donor and nitrogen acceptor. It also has an important role in controlling metabolic regulations of neurotransmitter glutamate. Because of the multiple functions and importance of GS in cellular metabolism, both catalytic activities and synthesis are highly regulated. The activity of GS is controlled by adenylylation. Its activity is decreased in the cerebral cortex of brains affected by Alzheimer's disease, particularly in the vicinity of senile plaques. It is also decreased under conditions of glucose deprivation.
仅用于科研。不用于诊断过程。未经明确授权不得转售。
生物信息学
蛋白别名: GLNA; Glutamate ammonia ligase; glutamate decarboxylase; Glutamate--ammonia ligase; glutamate-ammonia ligase (glutamine synthase); glutamate-ammonia ligase (glutamine synthetase); Glutamine synthetase; Glutamine synthetase (glutamate-ammonia ligase); glutamine synthetase 1; glutamine synthetase I; GS; Palmitoyltransferase GLUL; Proliferation inducing protein 43
基因别名: GLNS; GLUL; GS
UniProt ID: (Mouse) P15105, (Rat) P09606
Entrez Gene ID: (Mouse) 14645, (Rat) 24957




